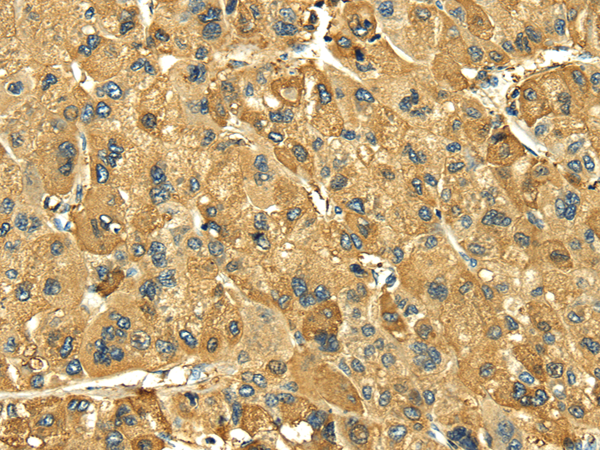

|
Background: |
This gene encodes a protein that is secreted by white adipocytes, and which plays a major role in the regulation of body weight. This protein, which acts through the leptin receptor, functions as part of a signaling pathway that can inhibit food intake and/or regulate energy expenditure to maintain constancy of the adipose mass. This protein also has several endocrine functions, and is involved in the regulation of immune and inflammatory responses, hematopoiesis, angiogenesis and wound healing. Mutations in this gene and/or its regulatory regions cause severe obesity, and morbid obesity with hypogonadism. This gene has also been linked to type 2 diabetes mellitus development. |
|
Applications: |
ELISA, IHC |
|
Name of antibody: |
LEP |
|
Immunogen: |
Full length fusion protein |
|
Full name: |
leptin |
|
Synonyms: |
OB; OBS; LEPD |
|
SwissProt: |
P41159 |
|
ELISA Recommended dilution: |
5000-10000 |
|
IHC positive control: |
Human liver cancer |
|
IHC Recommend dilution: |
30-150 |
購物車
幫助
021-54845833/15800441009
